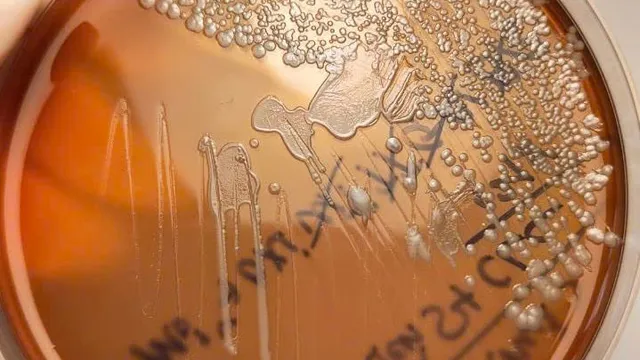
Cảnh giác với bệnh Whitmore

(Ảnh: ATTRAKT)
Kể từ khi ra mắt bản hit Cupid, FIFTY FIFTY đã liên tục phá vỡ hàng loạt kỉ lục trên các bảng xếp hạng âm nhạc. Trong tuần này, nhóm tiếp tục lập kỉ lục mới khi có tuần thứ 9 liên tiếp trụ hạng trên BXH uy tín Billboard Hot 100.
Cụ thể, theo thống kê từ Billboard, Cupid vẫn giữ vững phong độ ổn định ở hạng 18 trong tuần thứ 9 này. Đây cũng là ca khúc trụ hạng lâu nhất của một nhóm nhạc nữ K-Pop trong lịch sử bảng xếp hạng này. Trước đó, BLACKPINK là người nắm giữ kỉ lục này với bản hit Ice Cream kết hợp cùng Selena Gomez vào năm 2020.
Điều đáng chú ý hơn nữa là FIFTY FIFTY phá vỡ kỉ lục của BLACKPINK bằng một ca khúc không thêm sự kết hợp của bất kì nghệ sĩ nào. Hơn nữa, 4 cô gái cũng đến từ một công ty nhỏ tại Hàn Quốc và chỉ vừa ra mắt vào tháng 11/2022.
(Ảnh: Mnet)
Cupid cũng đang có sự tăng trưởng trên các đài radio tại Mỹ trong tuần này. Điều này dùn ca khúc leo hạng trên BXH Billboard Pop Airplay, từ vị trí 36 ở tuân trước lên thứ hạng 30 trong tuần này.
Như vậy, chỉ tính riêng đối với BXH Billboard Hot 100, FIFTY FIFTY đã phá vỡ nhiều kỉ lục. Vào tháng 3, FIFTY FIFTY trở thành nhóm nhạc K-Pop lọt top BXH này nhanh nhất, chỉ sau 4 tháng kể từ khi ra mắt. Sau nhiều tuần leo hạng ổn định, Cupid của nhóm tiếp tục lập thành tích, trở thành ca khúc không hợp tác đầu tiên của một nhóm nhạc nữ K-Pop lọt top 20 trên BXH. Cho tới thời điểm hiện tại, ca khúc vẫn trụ vững trong top 20 trong 3 tuần liên tiếp. Kỉ lục mới nhất nhóm nhận được chính là trở thành nhóm nhạc nữ K-Pop sở hữu ca khúc trụ hạng lâu nhất trên BXH Billboard Hot 100.
Ở thời điểm hiện tại, nhóm đang chuẩn bị cho các công đoạn quảng bá tại thị trường Mỹ và châu Âu.